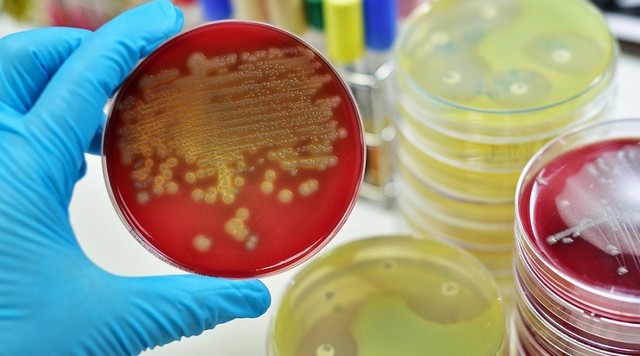
66385283_777012506028855_4648728715491016704_n

Загалом в рамках здійснення державного санітарно-епідеміологічного нагляду відбулося 245 планових та позапланових перевірок об’єктів. Інспектори побували у навчально-виховних, лікувально-профілактичних закладах, підприємствах питного водопостачання, суб’єктів господарювання, що використовують пестициди та агрохімікати тощо.
Як наслідок, порушення санітарних норм та правил виявлені у 50,6 % випадків:
- у лікувально-профілактичних закладах – 30 %,
- підприємствах централізованого водопостачання – 89 %,
- дошкільних навчальних закладах – 67 %,
- об’єктах поводження з пестицидами та агрохімікатами – 15 %.
Черкаська регіональна державна лабораторія Держпродспоживслужби впродовж першого півріччя поточного року дослідила 4727 проб питної води, харчових продуктів, готових страв, гігієнічних змивів, води поверхневих водойм, ґрунту.
Таки чином, гігієнічним вимогам за мікробіологічними показниками не відповідало 15,6 % проб питної води. За санітарно-хімічними показниками - 18,3 %.
У 9,7 % проб готових страв було виявлено відхилення від норм за мікробіологічними показниками.
1 % гігієнічних змивів та 5,4 % води поверхневих водойм не відповідали за мікробіологічними та санітарно-хімічними, 12,5 % - за паразитологічними показниками.
В результаті проведених перевірок за порушення санітарного законодавства на посадових осіб накладено 75 штрафів на загальну суму майже 20000 грн., керівникам суб’єктів господарювання направлено 151 припис, видано 7 розпоряджень щодо усунення порушень санітарних норм і правил.
За матеріалами Держпродспоживслужби притягнуто до дисциплінарної відповідальності 8 працівників навчально-виховних закладів та дитячих закладів відпочинку, 3 справи передано на розгляд правоохоронних органів.
На адресу органів влади, місцевого самоврядування, причетних управлінь, відомств, організацій направлено 967 інформацій з відповідними пропозиціями щодо вирішення актуальних питань у сфері забезпечення санітарного та епідеміологічного благополуччя населення.
За пропозиціями Держпродспоживслужби власники об’єктів відстороняли від роботи 165 працівників до проходження профілактичних медичних оглядів, тимчасово призупиняли експлуатацію 8 об’єктів, зняли з реалізації майже 700 кг недоброякісної продукції.
Крім того, було організовано проведення позачергового гігієнічного навчання з прийняттям заліків фахівцями Держпродспоживслужби 788 працівників з числа декретованих контингентів.
Пресслужба Головного управління Держпродспоживслужби в Черкаській області
реклама

